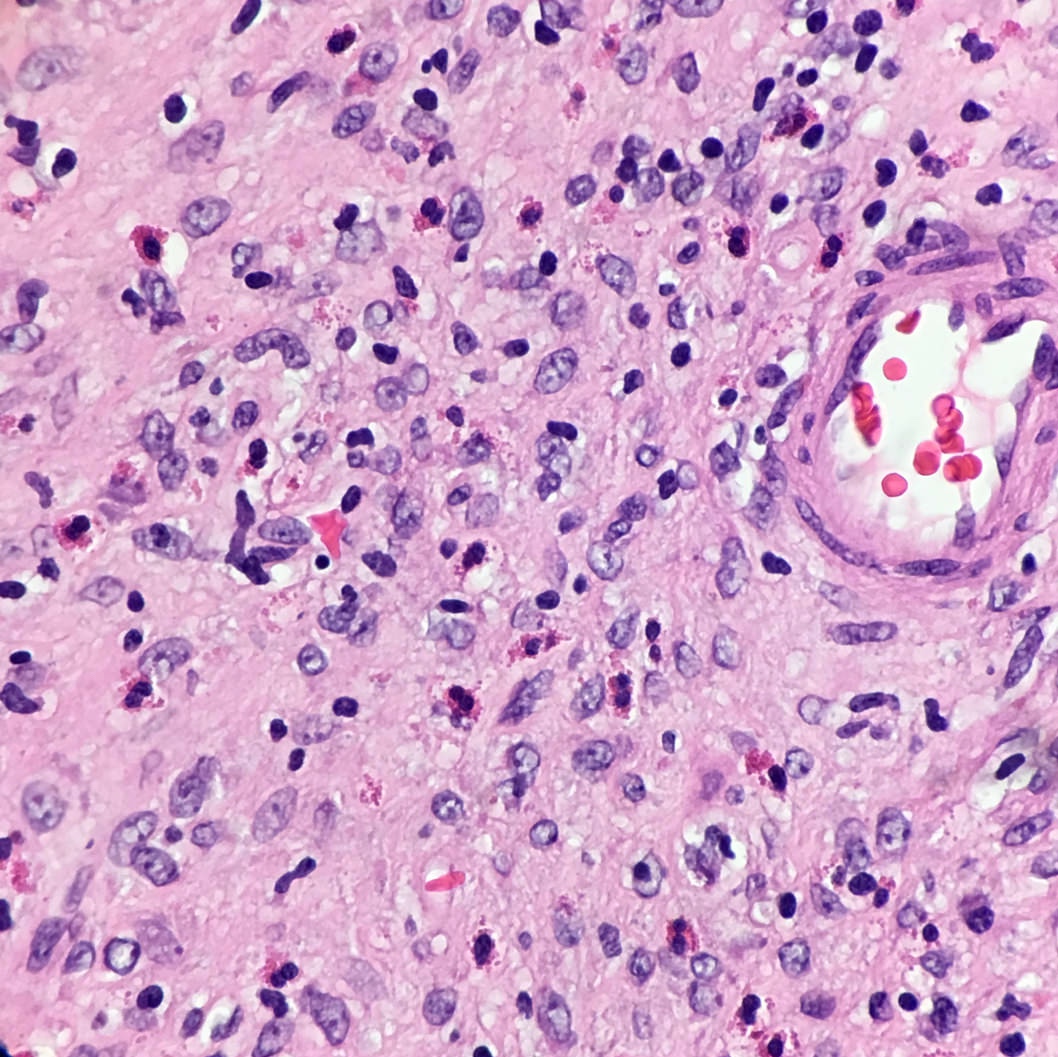

Table of Contents
Definition / general | Essential features | Terminology | Sites | Etiology | Clinical features | Case reports | Treatment | Gross description | Microscopic (histologic) description | Microscopic (histologic) images | Positive stains | Negative stains | Molecular / cytogenetics description | Sample pathology report | Differential diagnosis | Board review style question #1 | Board review style answer #1Cite this page: Assarzadega N, Gonzalez RS. Inflammatory fibroid polyp. PathologyOutlines.com website. https://www.pathologyoutlines.com/topic/stomachinflammatoryfibroid.html. Accessed April 25th, 2024.
Definition / general
- Benign neoplastic polyp that occurs anywhere in gastrointestinal tract but most commonly in stomach and small intestine
Essential features
- Benign mesenchymal gastrointestinal polyp that arises in the submucosa
- Associated with PDGFRA mutation
Terminology
- Also known as Vaněk polyps (Am J Pathol 1949;25:397)
- Formerly called eosinophilic granuloma
Sites
- Usually arises in pylorus or distal antrum in stomach
Etiology
- May be familial (Devon polyposis syndrome, Gut 1992;33:1004)
Clinical features
- Peak incidence in sixth or seventh decade of life
- No endoscopic surveillance is required after the histological diagnosis is confirmed
- Rarely associated with adenocarcinoma or adenoma (Arch Pathol Lab Med 1988;112:829)
Case reports
- 79 year old woman with chronic gastritis and a 2 cm sessile gastric polyp (Case #421)
Treatment
- Local excision
Gross description
- Typically solitary, small and sessile
- Median size 1.5 cm but can measure up to 9 cm
Microscopic (histologic) description
- Submucosal lesion composed of spindle and stellate stromal cells
- Loose edematous stroma containing thin walled blood vessels with characteristic onion skin arrangement of spindled cells around vessels
- Inflammatory infiltrate rich in eosinophils
- Can infiltrate lamina propria
- Minimal mitotic activity
Microscopic (histologic) images
Contributed by Naziheh Assarzadegan, M.D.
Case #421
Positive stains
- CD34, variable smooth muscle actin
Molecular / cytogenetics description
- Associated with activating mutation in the platelet derived growth factor receptor alpha (PDGFRA) gene, supporting a neoplastic origin (Histopathology 2012;61:59)
Sample pathology report
- Stomach, antrum, polypectomy:
- Inflammatory fibroid polyp (3.1 cm), focally extending to deep margin (see comment)
- Lateral margins unremarkable.
- Comment: An immunohistochemical stain for CD34 is positive.
Differential diagnosis
- Gastrointestinal stromal tumor:
- Plexiform fibromyxoma:
- Multinodular, centered on muscularis propria
- Lacks concentric vessels
- CD34-
- Schwannoma:
- Usually arise from muscularis propria
- Peripheral lymphoid cuffing
- S100+
Board review style question #1
Board review style answer #1
A. They are associated with activating mutation in the platelet derived growth factor receptor alpha gene
Comment Here
Reference: Inflammatory fibroid polyp
Comment Here
Reference: Inflammatory fibroid polyp